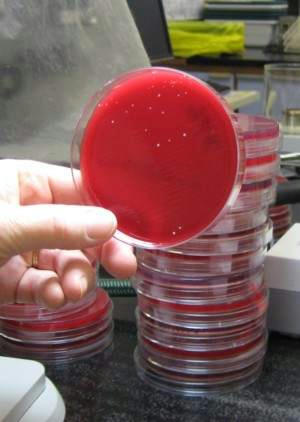
كشت ادرار در ازمايشگاه باكتري شناسي

سلام دوستان خوبید. وقت امتحانات است و همه جا سوتو کور شده مثل وبلاگ ما ... برای همه بچه های دانشجو آرزوی موفقیت داریم. بحثی که امروز می خواهم در این پست دنبال کنیم در مورد کشت سلولی ( یا همون کشت بافت Cell Culture ) هست. امروزه یکی از روش هایی که برای ایزوله کردن ویروس ها در آزمایشگاه های میکروب شناسی انجام می دهیم استفاده از محیط های کشتی است که حاوی سلول های خاص است. این محیط ها باعث می شود که ویروس ما در محیط آزمایشگاهی یا In Vitro رشد کرده و بتوانیم آن را ایزوله کنیم. شاید دانشجویان دوره کارشناسی علوم آزمایشگاهی مثل خودم تنها تئوری این مطالب را آموزش دیده اند ولی امروزه استفاده از این روش ها به امر رایجی در کشور های پیشرفته تبدیل شده است بنابراین تک تک ما باید نسبت به این روش ها آشنایی مقدماتی داشته باشیم. ویروس میکروارگانیمسی است که با نفوذ به سلول اثرات مختلفی را بر روی ماکرومولکول ها و پروتئین های سلول هدف می گذارد یکی از راه های تشخیص این ویروس ها توسط بررسی اثرات آنها بر روی سلول های محیط کشت است. انکلزیون ها یا تغییراتی که در سطح سلول ها می دهد برای شناسایی بسیاری از ویروس ها در کشت سلولی استفاده می شود.
کشت سلولی در واقع استفاده از سلول های یوکاریوت، پروکاریوت و یا گیاهی است که برای ایزوله کردن ویروس از آن ها استفاده می کنیم. این روش برای اولین بار در سال 1907 ( اگر درست یادم مونده باشه)توسط رز هانسون مورد استفاده قرار گرفت. نکته بسیار مهم در این کشت ها این است که باید شرایط تحت کنترل باشد و تمامی شرایط اپتیم برای سلول ها در دسترس باشد چون در اینجا بر خلاف محیط های کشت باکتریایی، محیط ما زنده است و باید مثل پرستار مراقب آنها باشیم. امروزه بیشتر از محیط های کشتی که از سلول های جانوران مشتق شده است استفاده می شود و در کشور ما هم در دسترس هستند مثلا DMEM , EMEM. به طور خلاصه از سه نوع سلول ( بر اساس شکل و ظاهر) در محیط های کشت سلولی استفاده می کنیم:
-
سلول های شبیه اپی تلیال( Epithelial-like cells)
-
سلول های شبیه لنفوبلاستی( Lymphoblast-like cells)
-
سلول های شبیه فیبروبلاستی( Fibroblastic)



قبل از معرفی این سلول ها دو تکنیکی که در کشت سلولی استفاده می شود را باید بهتون معرفی کنیم:
یکی استفاده از سلول های چسبنده (Adherent Cell ) است. به زبان ساده نحوه کشت در این تکنیک بدین صورت است که سلول ها به هم چسبیده هستند و به راحتی نمی شود آنها را پاساژ ( ساب کالچر- Sub culture ) داد چون این سلول ها در داخل فلاسک های کشت ما متصل هستند و زمانی که می خواهیم آنها را پاساژ دهیم( زمانی که سلول های ما در فلاسک به اصطلاح سرریز می شوند) باید سلول ها را از هم جدا کنیم ولی این به سختی انجام می گیرد. در دهه های گذشته یکی از پیشرفت های کشت سلولی همین مشکل ما را حل کرده است. بیولوژیست ها آنزیمی هایی مانند کلاژناز متصل به EDTA را تولید کرده اند که به وسیله آن می توانیم این سلول ها را از هم جدا کنیم از طریق جداسازی سلول ها از طریق هضم کردن ماتریکس بین سلولی. پس این روش متصل به سطح هست. راستی برای شستشوی سلول ها هم در کشت سلولی از محلول PBS استفاده می کنیم.
روش دیگر استفاده از سوسپانسیون است، این روش بر خلاف روش بالایی به راحتی پاساژ داده می شود چون مایع هست و نیازی به این همه سختی ندارد. در این روش یک سوم فلاسک را خالی می کنیم و سپس با محلول محیط اولیه خودمان ( که قبلا گرم شده است) آن را پر می کنیم. به همینراحتی می توان آن را پاساژ داد.
سلول های اپی تلیال و سلول های فیبروبلاست ( مثلا سلول های اپی تلیال کلیه میمون سبز آفریقایی که بهش Vero می گوئیم) در تکنیک اول یا همون سلول های چسبنده استفاده می شود در حالیکه از لنفوبلاست های معمولا در سوسپانسیون استفاده می شود.
از هر روشی که استفاده می کنیم به علت افزایش سلول ها و کاهش منابع غذایی باید سلول ها را ساب کالچر یا همان پاساژ داد. بدین ترتیب سلول ها در چرخه رشد خود باقی می مانند و نمی میرند. بعد از پاساژ دادن های مختلف بالاخره سلول های ما به دست می آید که به آنها لاین سلولی می گویند. در واقع ما در این لاین ها ویروس ها ( یا هر چیز دیگه که نیازش داریم ) را کشت می دهیم. این لاین های سلولی به صورت تجاری در دسترس هستند وانواع مختلفی دارند. با توجه به نوع سلولی که به آن نیاز داریم می توانیم از آنها استفاده کنیم. این چند نکته مواردی بود که الان تو ذهنم بود و براتون پست کردم اگر فرصت شد تو ادامه بیشتر در این زمینه بحث خواهیک کرد. از شما هم درخواست داریم که تجربیات خودتان در این زمینه را در اختیار بچه های علوم آزمایشگاهی قرار بدهید تا ما تازه وارد ها بیشتر با دنیای زیبای رشته خودمون آشنا شویم.